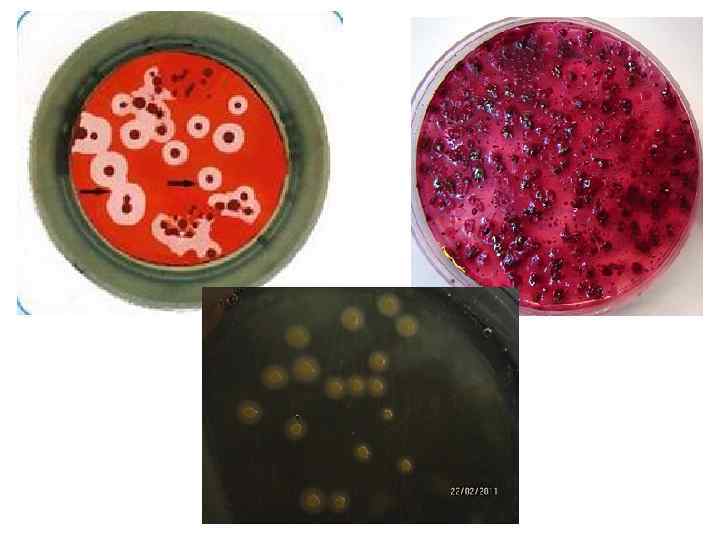
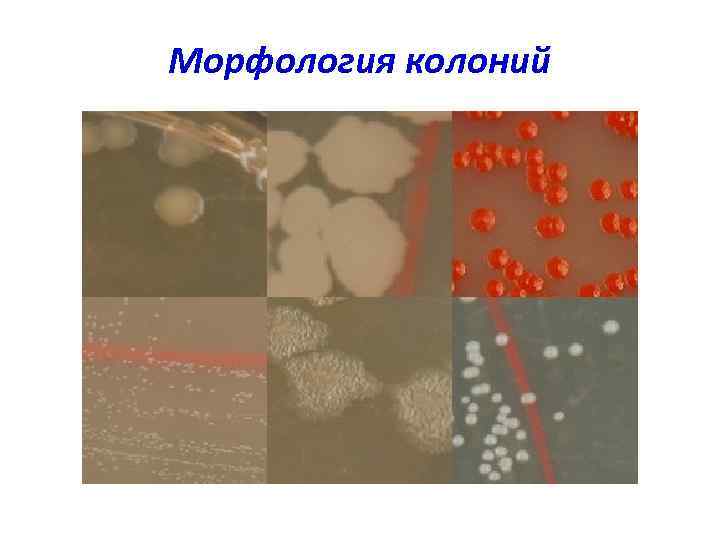
Морфология колоний
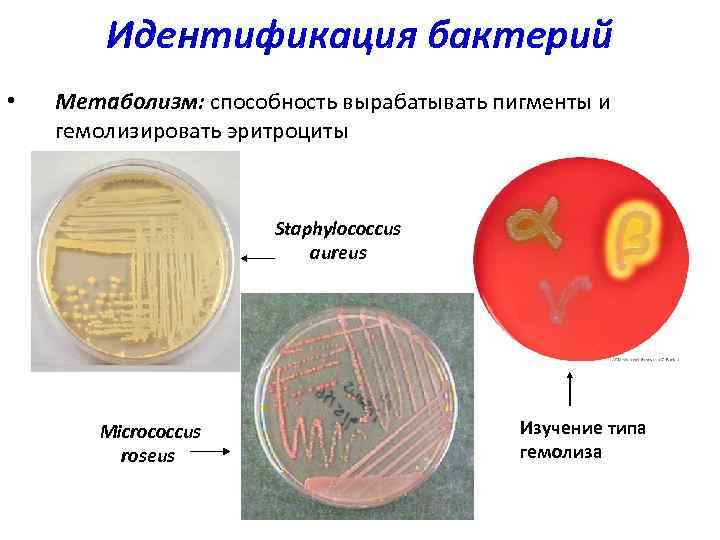
Идентификация бактерий • Метаболизм: способность вырабатывать пигменты и гемолизировать эритроциты Staphylococcus aureus Micrococcus roseus

Лекция-1 Стомат.pptx
- Количество слайдов: 60

Запорожский государственный медицинский университет Кафедра микробиологии, вирусологии, иммунологии Предмет и задачи микробиологии. Основные этапы развития. Систематика номенклатура и классификация микроорганизмов. Физиология бактерий. ас. Войтович А. В.

Разделы микробиологии: Общая изучает наиболее общие закономерности, свойственные микроорганизмам: структуру, метаболизм, генетику, экологию и т. д. Техническая - разработка биотехнологии синтеза микроорганизмами биологически активных веществ: белков, нуклеиновых кислот, антибиотиков и др. Сельскохозяйственная - роль микроорганизмов в круговороте веществ, использует их для синтеза удобрений, борьбы с вредителями. Ветеринарная - возбудителей заболеваний животных и т. д. Медицинская микробиология (в т. ч. клиническая) - изучает патогенные и условно–патогенные для человека микроорганизмы, разрабатывает методы специфической диагностики, профилактики и лечения. Санитарная микробиология - санитарно-микробиологическое состояние объектов окружающей среды, пищевых продуктов и напитков, и разрабатывает санитарно-микробиологические нормативы и методы индикации патогенных микроорганизмов в различных объектах и продуктах.

При этом наиболее близко к открытию микромира подошел итальянский врач Джироламо Фракасторо (1478— 1553). "О контагии, контагиозных болезнях и лечении" (1546) Предположил что инфекции вызывают маленькие тельца, передающиеся при контакте и сохраняющиеся на вещах больного. Дал название заболеванию сифилис.

Антони ван Левенгук (1632 -1723) голландский натуралист первый увидел и описал микробы.

24 апреля 1676 года даёт описание увиденных в капле воды существ, в том числе бактерий Письмо № 39, 17 сентября 1683 г.

Эдвард Дженер (1746 -1823) английский врач, первый внедрил в практику вакцину против натуральной оспы.

Луи Пастер (1822 -1895) французский микробиолог, ученый, химик и основоположник вакцинопрофилактики. • Самопроизвольное зарождение жизни • Болезни пива и вина (пастеризация) • Вакцина против куриной холеры, сибирской язвы • Вакцина против бешенства

Роберт Кох (1843 -1910) великий немецкий микробиолог. Основоположник медицинской микробиологии. В 1905 году Роберт Кох был удостоен Нобелевской премии по физиологии и медицине за открытие и выделение возбудителя туберкулёза

üОкраска бактерий анилиновыми красителями üТвёрдые питательные среды üИммерсионный объектив. üСформулировал критерии этиологической связи инфекционного заболевания с микроорганизмом (триада Коха). üВпервые выделил чистую культуру возбудителя сибирской язвы, доказал ее способность к спорообразованию. üСоздание вакцины против сибирской язвы üОткрытие холерного вибриона


Илья Мечников (1845 -1916) великий украинский, русский и французский биолог. Основоположник иммунологии и геронтологии. В 1908 году был удостоен Нобелевской премии по физиологии и медицине за открытие фагоцитоза

Дмитрий Ивановский (1864 -1920) Великий русский физиолог и микробиолог. Основоположник вирусологии. Открыл вирус табачной мозаики, который увидели только в 1939 году.

Ермольева З. В. (1898 -1974) Зильбер Л. А. (1894— 1966)

Украинские микробиологи Мечников И. И. Виноградский Сергей Николаевич (1856 - 1953) – открыл хемосинтез, впервые показал возможность получения энергии за счёт окисления сероводорода и использования её для ассимиляции углекислого газа. (1866 - 1929) – основоположник эпидемиологии, создал учение о природной очаговости чумы. Заболотный Даниил Кириллович (1888 - 1973) - Лауреат Нобелевской премии 1952 года по физиологии и медицине за открытие стрептомицина, первого антибиотик для лечения туберкулёза. Ваксман Зельман

Общая характеристика бактерий Характерные особенности • Отсутствие ядра • Наличие жгутиков, плазмид и газовых вакуолей • Формы размножения — бесполый способ. • Размер рибосомы — 70 s.

По форме выделяют следующие основные группы микроорганизмов. • 1. Шаровидные или кокки (с греч. зерно). • 2. Палочковидные. • 3. Извитые.

Основные формы бактерий

Кокковидные бактерии (кокки) по характеру взаиморасположения после деления подразделяются на: Микрококки Диплококки Стрептококки Тетракокки Сарцины Стафилококки

Палочковидные формы микроорганизмов Бактерии - палочки, не образующие спор. Бациллы - аэробные спорообразующие микробы. Клостридии - анаэробные спорообразующие микробы.

Извитые формы микроорганизмов Вибрионы и кампилобактерии - имеют один изгиб, могут быть в форме запятой, короткого завитка. Спириллы - имеют 2 - 3 завитка. Спирохеты - имеют различное число завитков, фибрилл. Borrelia, Treponema, Leptospira.

Методы исследования в микробиологии 1. Микроскопический (бактерио-, вирусоскопический): световая (в том числе фазово-контрастная и темнопольная микроскопия), люминесцентная иэлектронная микроскопия; 2. Микробиологический (бактериологический, вирусологический): выращивание микроорганизмов на питательных средах, культурах клеток и тканей, в курином эмбрионе; 3. Серологический: обнаружение антител в сыворотке крови человека и животных; 4. Аллергический: проведение накожных тестов с антигенами микроорганизмов; 5. Биологический: заражение лабораторных животных с воспроизведением инфекционного процесса на чувствительных моделях; 6. Молекулярно-генетический: обнаружение специфических генов микроорганизмов.

Микроскопы: 1. Световой (разрешающая способность – 200 нм). • иммерсионный; • фазово-контрастный; • темнопольный; • люминисцентный. 2. Люминесцентный. 3. Электронный (разрешающая способность – до 0, 0001 нм).

Строение бактериальной клетки Обязательные структуры: нуклеоид, цитоплазматическая мембрана, рибосомы. Необязательные структурные элементы: клеточная стенка, капсула, споры, пили, жгутики, плазмиды.

Схема строения бактериальной клетки

Капсулы Защита от высыхания, фагоцитоза. Адгезия

Споры служат для пережидания неблагоприятных условий

Кислотоустойчивые клеточные стенки

Жгутики и пили

Строение клеточной стенки бактерий

Окраска по Граму

Питание бактерий – процесс поглощения и усвоения пластичного материала и энергии в результате преобразовательных реакций.

• Бактерии по усвоению углерода 1. Автотрофы (литотрофы) получают углерод из неорганических соединений. 2. Гетеротрофы (органотрофы) используют в качестве источника углерода органические соединения.

• По источникам энергии: фототрофы – бактерии, для которых источником энергии является солнечный свет, и хемотрофы - бактерии, которые получают энергию за счет химического окисления веществ.

Механизмы проникновения питательных веществ в бактериальную клетку. • 1. Пассивная диффузия. • 2. Облегченная диффузия. • 3. Активный транспорт. • 4. Транслокация радикалов.

Питательные среды специально приготовленные субстраты для выращивания микробов в искусственных условиях.

Требования к питательным средам: 1) достаточное количество необходимых питательных веществ: • углерод, азот, • источники энергии, • минеральные соли, • ростовые факторы;

2) оптимальность р. Н для роста данного вида бактерий; 3) стерильность; 4) изотоничность; 5) прозрачность.

Классификация питательных сред По консистенции: • - жидкие; • - полужидкие; • - плотные;

ПИТАТЕЛЬНЫЕ СРЕДЫ • • • Простые мясо-пептонный бульон (МПБ) — жидкая среда мясо-пептонный агар (МПА) — плотная среда • Специальные - характеризуются добавлением специфического компонента или заменой основы. • • казеиново-угольный агар сывороточный агар кровяной бульон яичная среда Левенштейна-Йенсена • Элективные - характеризуются получением роста только интересующего микроорганизма. • • • желточно-солевой агар (ЖСА) — для стафилококка пептонная вода (1 %, p. H=8) — для холерного вибриона среда Мюллера — для сальмонелл селенитовая среда — для сальмонелл среда Леффлера — эффективна для коринебактерий дифтерии • Дифференциально-диагностические - позволяют произвести идентификацию отдельных типов, видов и групп бактерий. • • среды Гисса ( «пёстрый ряд» ) среда Сабуро — с добавлением антибиотика

Дыхание – процесс биологического окисления бактерий.

Классификация бактерий по типам дыхания • Аэробы – это большая часть бактерий, используют в процессе дыхания свободный кислород.

• Факультативные (необязательные) анаэробы могут существовать в присутствии и в отсутствии молекулярного кислорода. Таких патогенных микроорганизмов большинство.

• Облигатные (обязательные) анаэробы – бактерии, для которых наличие кислорода является вредным, оказывает токсическое действие на микроорганизм.

• Микроаэрофилы – нуждаются в кислороде, но лучше растут при повышенном содержании углекислого газа (геликобактер, цитробактерии и др. ).

Выделение чистых культур аэробов Метод Коха Метод Дригальского Метод Шукевича Выделение чистых культур анаэробов Физические методы Химические методы Биологический метод

Размножение это способность микроорганизмов к самовоспроизведению, увеличению количества особей на единицу объема.

Прокариоты размножаются бесполым путем: • • поперечное деление, фрагментация, почкование, бесполое спорообразование.

Принципы культивирования микроорганизмов Культивирование микроорганизмов - выращивание их в искусственных условиях.

Периоды роста бактерий в закрытой системе

КОЛОНИЯ • это видимое изолированное скопление представителей одного вида микроорганизмов, образующееся при размножении одной колониеобразующей единицы (КОЕ) на плотной питательной среде (на поверхности или в глубине её).

К О Л О Н И И • по величине — крупные (диаметр более 4— 5 мм), средние (2— 4 мм) и малые (1— 2 мм) • по форме — круглые, розеткообразные, листовидные и т. д. • по цвету, зависящему от пигмента — белого, ярко-синего, красного цветов и т. д. • по консистенции — сухие, влажные, сочные, слизистые • по поверхности — гладкие, морщинистые, исчерченные, плоские, выпуклые, плосковыпуклые, вдавленные • по краю — с ровными, волнистыми, бахромчатыми краями • по структуре — могут иметь аморфную, зернистую, волокнистую внутреннюю структуру • в чистой культуре, выращенной на скошенном питательном агаре, характер роста может быть сухим, влажным, ползучим, складчатым, пигментированным.

ИДЕНТИФИКАЦИЯ БАКТЕРИЙ Характер роста на плотной питательной среде: Форма колонии Поверхность Характеристика края колонии
Морфология колоний

Идентификация бактерий • Метаболизм: способность вырабатывать пигменты и гемолизировать эритроциты Staphylococcus aureus Micrococcus roseus Изучение типа гемолиза

ФЕРМЕНТЫ МИКРООРГАНИЗМОВ ГИДРОЛАЗЫ ОКСИДОРЕДУКТАЗЫ ИЗОМЕРАЗЫ ТРАНСФЕРАЗЫ ЛИГАЗЫ ЭНДОФЕРМЕНТЫ ЭКЗОФЕРМЕНТЫ АДАПТИВНЫЕ КОНСТИТУТИВНЫЕ

Ферменты патогенности бактерий Гиалуронидаза разрушает межклеточное вещество соединительной ткани (основой которого выступает гиалуроновая кислота). Нейраминидаза расщепляет сиаловую кислоту, входящую в состав поверхностных рецепторов клеток слизистых оболочек, что делает их доступными для взаимодействия с микробами и микробными токсинами. Фибринолизин растворяет сгусток фибрина в зоне воспаления, что создает условия для распространения микробов вглубь органов и тканей. Коллагеназа вызывает интенсивное расплавление мышечной ткани. Лецитиназа действует на лецитин мембран мышечных волокон, эритроцитов и других клеток. Коагулаза свертывает плазму крови. В результате вокруг бактериальной клетки формируется непроницаемый для антител и затрудняющий действие фагоцитов «чехол» . ДНК-аза деполимеризует ДНК. Протеазы разрушают антитела.

Определение вида бактерий. Среда Гисса
Лекция-1 Стомат.pptx